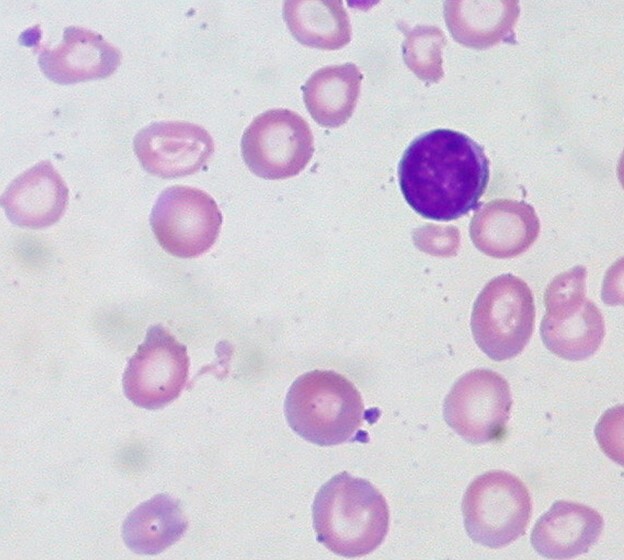
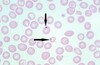

Hemoglobin electrophoresis categories:
Fetus
6 month old
Adult
Fetus: wide HbF (80%) + HbA (20%)
6 months: transition to HbA
Adult: HbA (96%) + HbA2 (2.5) + HbF (<1)

Hemoglobin electrophoresis categories:
B-thalassemia minor
B-thalassemia major
Minor: narrow HbA + wide HbA2
Major: wide HbA2 + Wide HbF

Hemoglobin electrophoresis categories:
Sickle Cell Disease
Sickle Cell Trait
HbC Disease
HbC Trait
HbSC Disease
SS: HbS
AS: HbA + HbS
CC: wide HbC
AC: HbA + HbC
SC: HbS + HbC

Left shift in the Hemoglobin O2 dissociation curve:
“HigH Mile Flyer Prices & Low Bus Prices”
High:
Hb affinity (poor tissue oxygenation)
Methemoglobin
HbF
Ph
Low:
2,3 BPG
POC

Right shift in the hemoglobin-O2 dissociation curve:
“low Health Prices & high Bus/TrAin ExPenses”
Low:
- Hb affinity (lots of tissue oxygenation)
- pH
High:
- 2,3-BPG
- Temperature
- Altitude
- Exercise
- PCO2

Anemia:
Iron deficiency
“Having Persistent Fatigue May HurT Playful Kids with a Low Feeling”

Hypochromic
Parllor
Fatigue
Microcytic
High TIBC
PICA
Koilomychia (spooning nails)
Low Ferritin
Anemia:
ACD (Chronic inflammation)
“CaN Cause InflaMmatioN, low TItre, & High Ferritin”
- Cancer
- Normocytic
- Inflammation
- Microcytic
- Non-hemolytic
- Low TIBC & Iron
- High Ferritin
Anemia:
Sideroblastic anemia
“captaIn MarVeL’s high FlIghT & low Tough BlowS”
Isoniazid (TB Rx.)
Microcytic
Vit B6 deficiency (biotin)
Lead poisoning
High Ferritin, Iron, & Transferrin
Low TIBC
Basophilic Stippling
Alpha-Thalassemia:
“ARMy NEws”
& subtypes:
Silent
A-thalassemia trait
HbH disease
Hydrops fetalis
Alpha-Thalassemia:
- Reticulocytosis
- Microcytic anemia
- Normal Hemoglobin Electrophoresis
Subtypes:
Silent (-a/aa) Asymptomatic
Trait: (–/aa Asian or -a/-a African) Asymptomatic/mild anemia
HbH: (–/-a) intermittent-severe chronic anemia
Hydrops: (–/–) fatal

A-Thalassemia:
HbH Disease
“HbH Causes Jaundice, HigHeR Problems & lower HeMe adHesion”
HbH on the heme electrophoresis
Chronic hemolysis
Jaundice
High HbH (hypoxia), Reticulocytosis, & Hepatosplenomegaly
Poikilocytosis
Low Hb, MCV, Hct
Differentials for Alpha vs Beta thalassemias
Alpha minor/trait
Alpha HbH disease
Beta minor/major
Alpha minor/trait:
MCV (Normal/low)
HbA2 (Normal/low)
HbF (Normal)
HbH (Maybe present)
Alpha HbH disease:
MCV (Low)
HbA2 (Normal/low)
HbF (Normal/low)
HbH (Present)
Beta minor/major:
MCV (Low)
HbA2 (High)
HbF (High)
HbH (Absent)
Alpha-Thalassemia:
Hydrops Fetalis
“HuSHPuppiEs”
Hepatosplenomegaly
Heart failure
Edema
Prenatal death
Severe hypoxia
B-Thalassemia: ~6MONTHS
Minor
“Minor Melon RINds Have lower Healthy Minerals”
vs
Major
“My Terrible STD Penis gets BITCHeD & NoT CHuCked”
Minor: 1 allele deletion
Microcytic
Mild Anemia
Normal Reticulocytosis + Iron
Low Hb, Hct, MCV
Major: 2 allele deletion
Microcytic
Target cells
Severe Transfusion-Dependent anemia
Poikilocytosis
Transfused patients (Bronze pigmentation, Iron overload, Cardiomegaly, Hypogonadism, Diabetes)
Not Transfused (Crew-cut skull, Hepatosplenomegaly, Cardiac failure)
Sickle cell disease
“I CHANCeD An Proper Actual Home with BJs
Triggers: Infection dehydration, Hypoxia
Hemolytic anemia
Cholecystitis
Microvascular ischemia
Acute chest syndromes (bone pain)
Autosplenectomy
Poikilocytosis
Crew-Cut skull
Normocytic
Howell-Jowell bodies

Hemophilia A, B, C
A: VIII
B: IX
C: XI
Inactive II, VII, IX, X, C, S are turned into active carboxylated clotting factors & anticoagulants (C,S) via which enzyme:
Y-glutamyl carboxylase (Vit K dependent)
Extrinsic pathway (Tissue injury)
Factors:
Test:
Factors: VII goes to –> VIIa —>X
Prothrombin time test

Intrinsic pathway (Collagen, basement membrane, & activated platelets)
Factors:
Test:
Factors:
XII (XIIa) –> XI (XIa) –> IX (IXa) –> VIIIa
Activated Partial Thromboplastin Time (aPTT/PTT)

Common hemostasis pathway:
Factors:
X (Xa) –> II (Prothrombin) –> IIa (Thrombin)
–> I (Fibrinogen) —> Ia (Fibrin monomers) –> aggregation + Ca2+ & IIa (thrombin) activates XIIIa (XIIIa fibrinogen stabilizing factor)
–> Fibrin mesh for platelet plug
XIIa activates the kininogen system (aka Kinin cascade) & Plasminogen.
Kinin cascade:
HMWK –> (via Kallikrein) Bradykinin (more vasodilation, perm, pain)
Plasminogen:
Plasminogen –> (via tPA) Plasmin
Plasmin helps degrade fibrin mesh into D-dimers

Von Willebrand Disease (VIII)
“Poor PaTienTs BuTts get NePTunes PeaChy kiss,r wiPes with lower the PApeR towel”
- Def factor VIII (No platelet adhesion)
Prolonged:
PTT, BT
Normal:
PT, Platelet count
Low:
Platelet aggregation + Ristocetin

Vitamin K deficiency can be due to
“Dunk My WIenER In HaBanaro & PuT NoRi & PeanuTTs”
Diet (dark greens)
Malabsorption (pancreatic insufficiency)
Warfarin (inhibits Epoxide Reductase)
Bleeds (Hemarthosis, bleeding joints)
Prolonged PT/NR (Extrinsic coagulation pathway)
Prolonged PTT (Intrinsic coagulation pathway
Adrenal cortex
“GAMeR gAl FuCks GAy Cock & RiDes All Cock”
salty–> sweet –> sex
Glomerulosa
- Aldosterone
Mineralocorticoids
- reg via Angiotensin II
Fasciculata
- Cortisol
Glucocorticoids
- Reg via ACTH & CRH
Reticularis
- DHEA
Adrogen
- Reg via ACTH & CRH
common steps in Steroid hormone synthesis
Cholesterol (3)
Cholesterol hydroxylation
Pregnenolone
Cholesterol:
- Stored as CE’s
- De novo synthesis
- Uptake LDL via LDL receptors
Cholesterol hydroxylation:
Pregnenolone via desmolase (CYP11A + NADPH) RLS induced by ATCH & Angiotensin II
Pregnenolone:
Progesterone via 3-Beta-Hydroxysteroid Dehydrogenase (3BHSD)